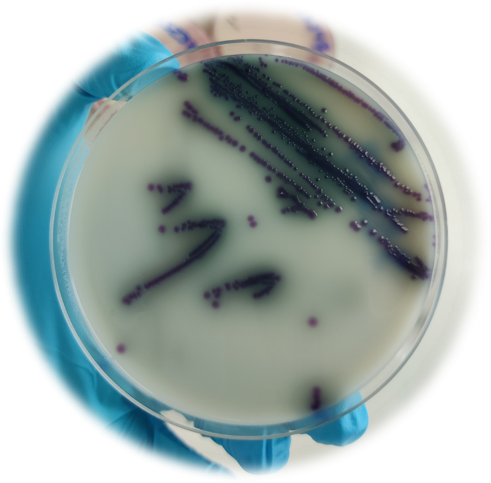
Technical advice: Controlling Salmonella in laying hens

Salmonella monitoring and differentiation tests are key to controlling the bacteria in laying hens
Salmonella enterica is a gram-negative enterobacteria with many different serovars affecting both humans and animals. Within poultry, Salmonella is divided into two groups: non-typhoid Salmonella and typhoid Salmonella.
Non-typhoid Salmonella are typically serovars that are a food safety issue as they cause severe infections such as diarrhoea, fever and stomach cramps in humans, for example Salmonella Enteritidis and Salmonella Typhimurium that do not necessarily cause disease in laying birds.
Typhoid Salmonella are relevant, host-specific serovars that only cause disease in chickens, such as Salmonella Gallinarum and Salmonella Pullorum.
Salmonella bacteria are well adapted to persisting in poultry environments. Biosecurity will always be a fundamental pillar in the control of Salmonella in poultry environments, with many aspects needing to be considered.
When it comes to the movement of personnel on to and around the farm, there are two main areas of consideration. The first point of biosecurity is the farm entrance; this should include barriers and cleaning and disinfection points for both vehicles and people. All personnel entering the site should be required to wash their hands and change to site-specific footwear and overalls.
The second point of biosecurity is the entrance to the poultry house – this should include changing boots and overalls and washing hands.
As part of Salmonella control, due care and attention also needs to be given to the control of rodents, insects, and wild birds, with steps taken to reduce and discourage their presence on farm as Salmonella can be easily replicated in these species and be widely spread to chickens.
Another pillar of protection is vaccination against Salmonella, specifically for the serovars of concern for human food safety. A requirement of the UK Lion Code is that all laying flocks are vaccinated against Salmonella Enteritidis and Salmonella Typhimurium during the rearing period, using a vaccine that is approved by the VMD and administered as per the manufacturer’s recommendations.
Ensuring that all vaccines are applied correctly is essential for their efficacy. With live Salmonella vaccination administered through the drinking water, care needs to be taken to not kill the vaccine strain. Several precautions must be taken.
No antibiotics should be given at least three days before or after vaccination. Competitive exclusions products (probiotics) should not be given for at least three days before vaccination. Water sanitisers should be removed at least 24 hours before vaccination. During the vaccination, water stabilisers should be used to remove any chlorine or heavy metals present in the birds’ drinking water.
Animal health companies have active poultry teams that are always willing to visit farms for training and auditing the vaccination process to ensure the best possible uptake of vaccine is obtained. To ensure continued food safety and maintain consumer confidence in the poultry industry, regular environmental sampling for Salmonella is undertaken. For laying hens enrolled in the Lion Code, this means sampling every 15 weeks, starting at 22-26 weeks of age.
Occasionally, during routine sampling, vaccine strains of Salmonella can be detected. To assist laboratories in detecting these cases, Ceva Animal Health provides two different tests to differentiate the Cevac Salmovac strain from field strains of Salmonella Enteritidis.
The first is the IDT Salmonella Diagnostic Kit, which consists of two vials: Medium A without adenine and histidine Medium B with adenine and histidine As the Cevac Salmovac vaccine strain has undergone a double chemical auxotropy it requires both adenine and histidine for growth and will only grow in medium B.
Wild Salmonella Enteritidis strains will grow successfully in both media, while an auxotrophic wild strain will not grow in either. In addition to the IDT Kit, Ceva Animal Health is to launch a new differentiation test using a chromogenic media, ASAP Medium, that demonstrates a unique colour for growth of the Cevac Salmovac strain.
Field strains of Salmonella grow as red and pink colonies, whereas Ceva Salmovac grow as dark, blue and green colonies. The ASAP medium is also a useful tool for monitoring Cevac Salmovac drinking water vaccination.
The identification of Cevac Salmovac strains during routine sampling is not a cause for concern with regards to food safety and can provide you with reassurance that the vaccine has been well administered during the rearing period.
Continued vigilance in the prevention and control of Salmonella throughout the supply chain maintains consumer confidence in the industry and ensures the UK remains a global example of the success of Salmonella control programmes.